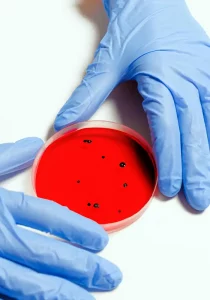

In diesem Bereich unserer Website finden zu Sie grundlegende Informationen zu verschiedenen sexuell übertragbaren Infektionen bzw. Krankheiten. Diese sollen Ihnen helfen, Risiken zu erkennen und darauf reagieren zu können. Zunächst finden Sie hier einen Überblick, über den Sie zu den entsprechenden weiterführenden Informationen gelangen können.
Facharzt für Innere Medizin - Infektiologie